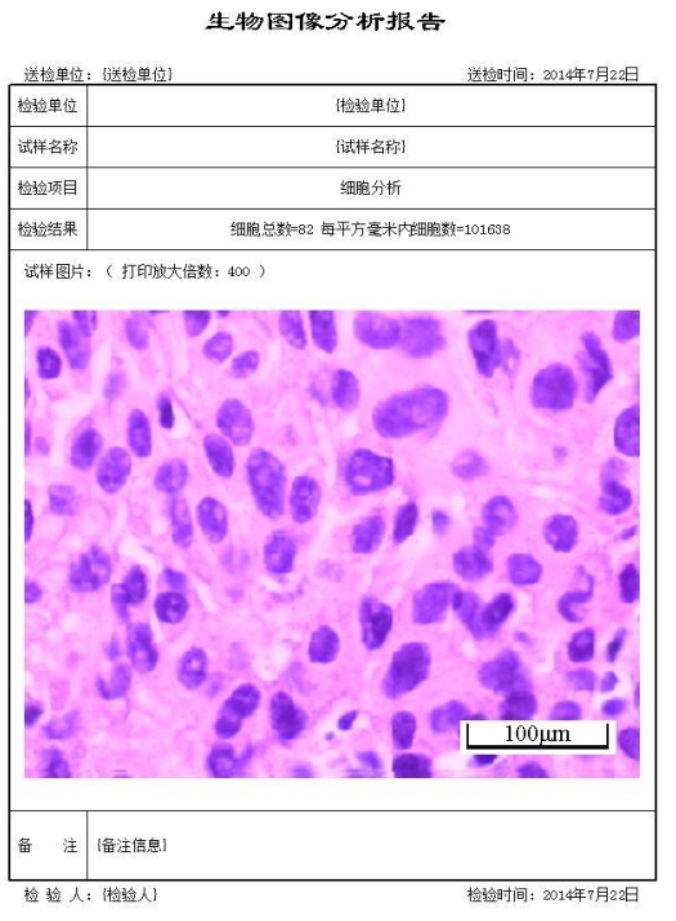

乐鱼leyu(中国)
当前位置:首页 > 乐鱼leyu(中国) > 显微视频图像系统 > DB-3000显微图像分析软件/生物图像分析软件/细胞统计软件

产品分类
相关新闻
Related Articles详细介绍
一、DB-3000显微图像分析软件特点:
DB-3000显微图像分析软件为正版软件,有相关证书,证书可查询,加密锁编号独立,可在软件界面实时采集显微照片,终身提供免费升级服务。
《DB-3000显微图像分析软件》是专门为从事生物领域分析要求开发的一套计算机软件系统。软件具备多种生物图像分析功能,可按客户要求定性开发。它的基本原理是:通过显微镜将显微图像拍摄下来,再对该图片进行自动分析,得到相关检验结果。
二、 DB-3000显微图像分析软件主要功能:
⒈自动分析:
本软件以用户需求为依据,开发出了专用的图像分析软件功能模块,用户可在本软件的帮助下,完成显微图像分析工作,功能如下:
1、细胞分析:对深色或浅色细胞自动统计细胞总数,每平方毫米内细胞数,单个细胞的直径及面积。
2、菌群分析:对稀疏菌群或密集菌群自动统计细菌总数,每平方毫米内细菌数,单个细菌的直径及面积。
3、免疫组化:提取各个成分的基本色,搜索出该成分在图像上对应的面积,百分比,颗粒数。
4、成份分析:提取各个成分的基本色,搜索出该成分在图像上对应的面积,百分比,颗粒数。
5、颗粒分析:软件自动提取颗粒,并可设置区域,得出每个区域的颗粒数,面积及百分比。
6、图像叠加:软件搜索得出第一张显微照片上的轮廓,再装入第二张图像,软件将第一张照片搜索出来的轮廓线,投影到第二张图像,同时计算出每个轮廓投影的周长,面积等值。
2、图像处理:
由于样品制备及拍摄的原因,为了更方便分析,拍摄下来的显微照片可用本软件进行处理。软件提供了上百种图像处理方法,如亮度调整、对比度调整、颜色调整、转换为灰度图像、灰度自动色阶、二值化处理、去除杂点、连接断线、反相、通道、锐化、柔化、边缘增强、中值滤波去噪等处理和调节图像的方法。
3、几何测量功能:
本软件提供了:“点”、“直线”、“矩形”、“圆”、“多边形”、“角度”等多种测量工具及测量方法,可完成长度、面积、角度等测量工作。可在测量图上备注文字,标尺,设定固定倍数等。测量完成后可通过软件功能生成一份单图或多图的测量报告。
产品咨询
乐鱼官方网页版
乐鱼官方网页版 公司地址:上海市嘉定区顺达路98弄南翔现代企业园41号 技术支持:化工仪器网扫一扫 更多精彩
微信二维码
网站二维码